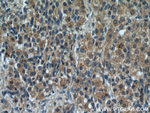
GREM2 Antibody in Immunohistochemistry (Paraffin) (IHC (P))

Search
Proteintech
GREM2 Polyclonal Antibody
{{$productOrderCtrl.translations['antibody.pdp.commerceCard.promotion.promotions']}}
{{$productOrderCtrl.translations['antibody.pdp.commerceCard.promotion.viewpromo']}}
{{$productOrderCtrl.translations['antibody.pdp.commerceCard.promotion.promocode']}}: {{promo.promoCode}} {{promo.promoTitle}} {{promo.promoDescription}}. {{$productOrderCtrl.translations['antibody.pdp.commerceCard.promotion.learnmore']}}
产品信息
13892-1-AP
种属反应
已发表种属
宿主/亚型
分类
类型
抗原
偶联物
形式
浓度
规格
纯化类型
保存液
内含物
保存条件
运输条件
产品详细信息
Immunogen sequence: AIHSPYKDG SSNNSERWQH QIKEVLASSQ EALVVTERKY LKSDWCKTQP LRQTVSEEGC RSRTILNRFC YGQCNSFYIP RHVKKEEESF QSCAFCKPQR VTSVLVELEC PGLDPPFRLK KIQKVKQCRC MSVNLSDSDK Q (29-168 aa encoded by BC046632)
靶标信息
GREM2 encodes a member of the BMP (bone morphogenic protein) antagonist family. Like BMPs, BMP antagonists contain cystine knots and typically form homo- and heterodimers. The CAN (cerberus and dan) subfamily of BMP antagonists, to which this gene belongs, is characterized by a C-terminal cystine knot with an eight-membered ring. The antagonistic effect of the secreted glycosylated protein encoded by this gene is likely due to its direct binding to BMP proteins. As an antagonist of BMP, this gene may play a role in regulating organogenesis, body patterning, and tissue differentiation.
仅用于科研。不用于诊断过程。未经明确授权不得转售。
生物信息学
蛋白别名: CKTSF1B2FLJ21195; Cysteine knot superfamily 1, BMP antagonist 2; DAN domain family member 3; DAND3Prdc; gremlin 2, cysteine knot superfamily, homolog; Gremlin-2; Gremlin1; PRDC; PRDCgremlin 2; Protein related to DAN and cerberus; unnamed protein product
基因别名: CKTSF1B2; DAND3; GREM2; Gremlin2; PRDC; STHAG9
UniProt ID: (Human) Q9H772, (Mouse) O88273
Entrez Gene ID: (Human) 64388, (Mouse) 23893